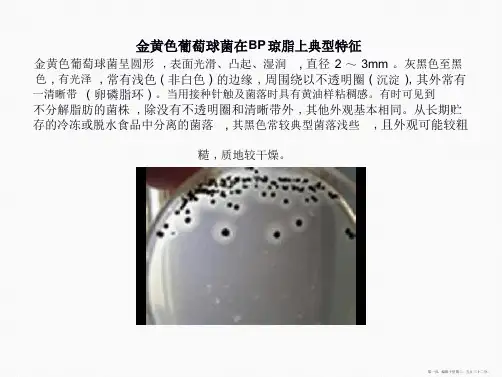

金黄色葡萄球菌典型特征图集讲解
- 格式:ppt
- 大小:2.34 MB
- 文档页数:8



金色葡萄球菌介绍及图片简介金色葡萄球菌金黄色葡萄球菌(Staphyloccocus aureus Rosenbach) 是人类的一种重要病原菌,隶属于葡萄球菌属(Staphylococcus),可引起多种严重感染。
有“嗜肉菌"的别称。
菌类介绍细菌按形态可分为:球菌,杆菌,和螺旋菌.金黄色葡萄球菌就是球菌的一种.它是革兰氏阳性菌的代表.革兰氏阳性菌就是可以被结晶紫初染,碘液媒染,乙醇处理,沙黄(红色)复染后呈现紫红色的细菌.而革兰氏阴性菌则呈现红色.这些差别源于金黄色葡萄球菌细胞壁的组成和结构不同.金黄色葡萄球菌细胞壁含90%的肽聚糖和10%的磷壁酸.其肽聚糖的网状结构比革兰氏阴性菌致密,造成了不同的染色结果.金黄色葡萄球菌与青霉素的发现有很大的渊源.当年弗莱明就是在他的金黄色葡萄球菌的培养皿中发现有些球菌被杀死了,于是发现了青霉素.而研究也表明青霉素只对以金黄色葡萄球菌为代表的革兰氏阳性菌作用明显.这也是由肽聚糖层的厚度和结构造成的。
生物学特性典型的金黄色葡萄球菌为球型,直径0.8μm左右,显微镜下排列成葡萄串状。
金黄色葡萄球菌无芽胞、鞭毛,大多数无荚膜,革兰氏染色阳性。
金黄色葡萄球菌营养要求不高,在普通培养基上生长良好,需氧或兼性厌氧,最适生长温度37°C,最适生长pH 7.4,干燥环境下可存活数周。
平板上菌落厚、有光泽、圆形凸起,直径1~2mm。
血平板菌落周围形成透明的溶血环。
金黄色葡萄球菌有高度的耐盐性,可在10~15%NaCl肉汤中生长。
可分解葡萄糖、麦芽糖、乳糖、蔗糖,产酸不产气。
甲基红反应阳性,VP反应弱阳性。
许多菌株可分解精氨酸,水解尿素,还原硝酸盐,液化明胶。
金黄色葡萄球菌具有较强的抵抗力,对磺胺类药物敏感性低,但对青霉素、红霉素等高度敏感。
感染与致病机理金黄色葡萄球菌是人类化脓感染中最常见的病原菌,可引起局部化脓感染,也可引起肺炎、伪膜性肠炎、心包炎等,甚至败血症、脓毒症等全身感染。